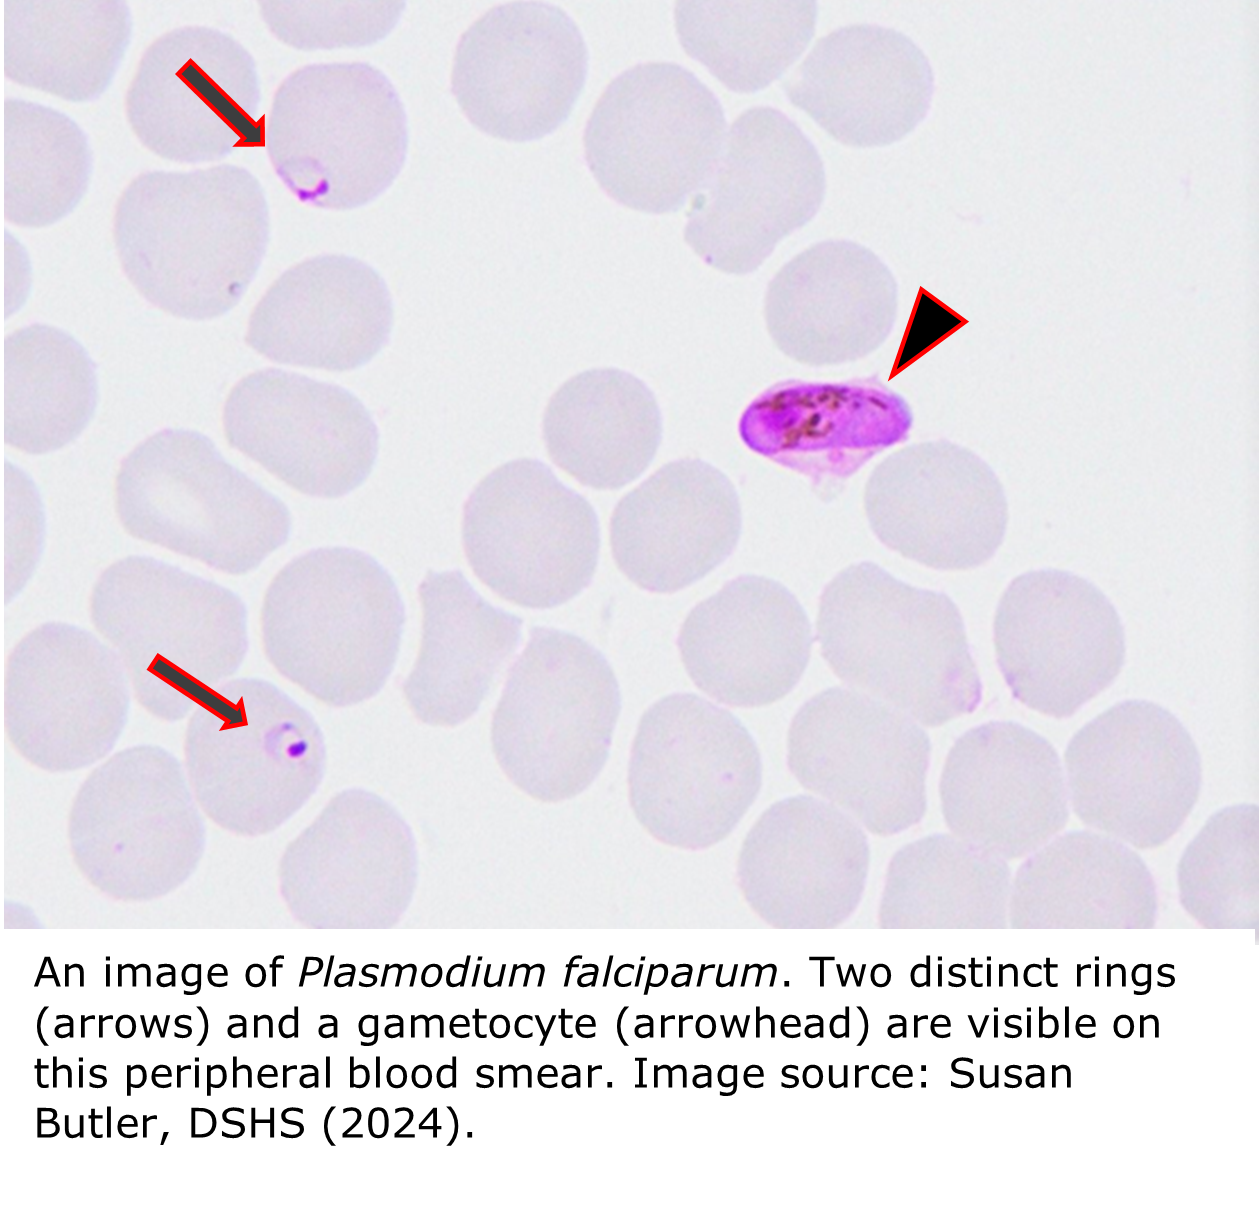

Parasite Testing at DSHS Laboratory
This page provides information about Parasite Testing at DSHS Laboratory .
Parasite Testing at DSHS Laboratory
|
The DSHS Laboratory does not accept parasitology specimens from the public. Only healthcare providers can order parasitology tests and submit specimens for testing. Specimens submitted by the public will be rejected and destroyed. If you believe you have a parasitic infection, please talk with your healthcare provider. Laboratory staff cannot provide medical advice. Your provider will contact the DSHS Parasitology Laboratory for specimen submission requirements, if needed. |
Parasites can be divided into two large groups: Protozoa and Helminths (worms). Both protozoa and helminths can be free-living or parasitic. Transmission of protozoa and helminths that infect the intestines typically happens via the fecal-oral route (when food or water contaminated by feces is ingested). Protozoa that infect the blood or other human tissues are usually spread by biting insects such as mosquitos, kissing bugs, and sandflies.
The DSHS Parasitology Laboratory tests for and identifies several medically important parasites, some of which must be reported to local and regional health departments. In such cases, the disease reporting contact, typically an epidemiologist, of the patient’s county of residence must be notified of the confirmed positive case.
A list of Texas notifiable conditions is at IDPS | Notifiable Conditions (state.tx.us). You may also scan the QR code for the list.

Parasite Diseases of Medical Importance in Texas
Note: The inclusion of external weblinks is for informational purposes only. The links do not represent an endorsement by Texas DSHS of any goods and/or services provided by these entities. These external sites may also not be accessible to people with disabilities.
 Amebiasis is an intestinal infection caused by the microscopic parasite Entamoeba histolytica. Several species of Entamoeba can live in humans, but not all cause disease. Amebiasis is more common in developing countries but occurs in the United States too. E. histolytica is transmitted in water contaminated with human feces and can cause amoebic dysentery. The parasite’s cysts and trophozoites (an amoeba growth stage) are passed from the body in feces.
Amebiasis is an intestinal infection caused by the microscopic parasite Entamoeba histolytica. Several species of Entamoeba can live in humans, but not all cause disease. Amebiasis is more common in developing countries but occurs in the United States too. E. histolytica is transmitted in water contaminated with human feces and can cause amoebic dysentery. The parasite’s cysts and trophozoites (an amoeba growth stage) are passed from the body in feces.
A person becomes infected by ingesting mature cysts from fecally contaminated food, water, or surfaces. Once inside the body, E. histolytica cysts release trophozoites into the small intestine, which migrate to the large intestine. A severe infection can cause abdominal pain, profuse diarrhea, fever, and bloody stools. A person can be infected without symptoms (asymptomatic carrier) if trophozoites remain in the large intestine. In some cases, trophozoites can cross the intestinal wall and travel to other parts of the body such as the liver, lungs, brain, or heart, where they can form abscesses.
Amebiasis Testing at DSHS Austin Laboratory
The DSHS Laboratory conducts fecal ova and parasite morphological exams for Entamoeba species. The Laboratory also forwards E. histolytica/E. disbar specimens to CDC for molecular testing (real-time PCR).
Please refer to the DSHS LTSM test menu for more details on E. histolytica testing at the Laboratory. Specimen submission guidance is available on DSHS’ specimen submission and shipping requirements pages. Healthcare providers should submit E. histolytica and E. disbar specimens to DSHS Laboratory for forwarding to CDC. Please do not send any specimens directly to CDC without first obtaining pre-approval from CDC.
For more resources on amebiasis, visit DSHS’ Infectious Disease Control’s webpages at https://www.dshs.texas.gov/IDCU/disease/Amebiasis.aspx and CDC at CDC - DPDx - Amebiasis.
 Chagas disease is a vector-borne illness caused by the protozoan parasite Trypanosoma cruzi. The bite of a Triatomine bug is the primary mode of transmission of T. cruzi to humans and animals. The parasite is found in the feces of the Triatomine bug. It enters the body through the bite wound when the bitten individual scratches the irritated skin. Once inside the body, the parasite can travel in the bloodstream and infect different tissues and organs including smooth muscle and the heart, possibly causing cardiac, intestinal, and neurological inflammation.
Chagas disease is a vector-borne illness caused by the protozoan parasite Trypanosoma cruzi. The bite of a Triatomine bug is the primary mode of transmission of T. cruzi to humans and animals. The parasite is found in the feces of the Triatomine bug. It enters the body through the bite wound when the bitten individual scratches the irritated skin. Once inside the body, the parasite can travel in the bloodstream and infect different tissues and organs including smooth muscle and the heart, possibly causing cardiac, intestinal, and neurological inflammation.
 Chagas disease is reportable in Texas. Confirmed and suspected positive cases of Chagas disease must be reported to the local or regional health department in the county of the patient’s residence within one week. The Laboratory encourages providers to submit serum and plasma specimens linked to reported cases of Chagas disease to the DSHS Laboratory.
Chagas disease is reportable in Texas. Confirmed and suspected positive cases of Chagas disease must be reported to the local or regional health department in the county of the patient’s residence within one week. The Laboratory encourages providers to submit serum and plasma specimens linked to reported cases of Chagas disease to the DSHS Laboratory.
DSHS Zoonosis Control, in partnership with CDC, provides Triatomine bug testing for the presence of Trypanosoma cruzi. Due to laboratory workload and budget constraints at CDC, only bugs implicated in human exposure are accepted for testing. This free service is for Texas residents only. Refer to DSHS Zoonosis Control’s Chagas Disease page at Triatomine Submission and Testing | Texas DSHS for additional information. For more information on Chagas Disease, visit CDC - DPDx - American Trypanosomiasis.
Chagas Disease Testing at DSHS Austin Laboratory
Serologic screening for chronic Chagas disease is available at DSHS Austin Laboratory. The Laboratory can also forward serum specimens from healthcare providers and laboratories to CDC for confirmatory serologic testing for chronic Chagas disease. Additionally, CDC offers molecular testing (PCR) for acute or congenital Chagas disease on DSHS referred specimens. Please refer to the DSHS LTSM test menu for submission details for Chagas testing at the Laboratory.
Cryptosporidiosis is a diarrheal illness caused by protozoan parasites of the genus Cryptosporidium. The parasite and illness are commonly referred to as “crypto.” Cryptosporidiosis can be spread through water or food that is contaminated with feces containing Cryptosporidium oocysts. On rare occasions, infections can be spread through sexual contact. Once inside the body, the parasites attach to the epithelial cells of the small intestine, causing abdominal pain and diarrhea.
 Exposure to contaminated surface or recreational waters, such as lakes, splash pads and swimming pools, as well as consuming contaminated water are common ways crypto is spread. Different species of the parasite can infect birds, mammals, and reptiles. Cattle, sheep, and goats are significant sources of the species that infects humans.
Exposure to contaminated surface or recreational waters, such as lakes, splash pads and swimming pools, as well as consuming contaminated water are common ways crypto is spread. Different species of the parasite can infect birds, mammals, and reptiles. Cattle, sheep, and goats are significant sources of the species that infects humans.
 Cryptosporidiosis is reportable in Texas. Confirmed and suspected positive cases of cryptosporidiosis must be reported to the local or regional health department for the county of the patient’s residence within one week. The Laboratory highly encourages providers to submit all specimens linked to reported cases of cryptosporidiosis to the DSHS Laboratory.
Cryptosporidiosis is reportable in Texas. Confirmed and suspected positive cases of cryptosporidiosis must be reported to the local or regional health department for the county of the patient’s residence within one week. The Laboratory highly encourages providers to submit all specimens linked to reported cases of cryptosporidiosis to the DSHS Laboratory.
For more information on cryptosporidiosis in Texas and the United States please refer to the following resource links:Cryptosporidiosis | Texas DSHS and CDC - DPDx - Cryptosporidiosis.
Cryptosporidium Testing at DSHS Austin Lab
Cryptosporidium detection and identification testing is available at the DSHS Austin Laboratory. The Laboratory also tracks the spread of cryptosporidium in Texas and can identify species, genotypes, and subtypes of Cryptosporidium parasites in outbreaks as part of CDC’s CryptoNet molecular surveillance program for parasitic infections.
- Refer to the DSHS LTSM test menu for more details on Cryptosporidium testing at the DSHS Laboratory.
- More information on the CryptoNet program and submitting specimens for surveillance purposes may be found here.
 Cyclosporiasis is a foodborne illness caused by the protozoan Cyclospora cayetanensis. The parasite enters the body when a person ingests food or water contaminated with feces containing Cyclospora oocysts. Outbreaks of cyclosporiasis have been associated with eating certain types of imported fresh produce, in particular fresh cilantro, pre-packaged salad mix, raspberries, basil, snow peas, and various lettuces. Due to the Cyclospora lifecycle, it is unlikely the parasites can be spread through direct person-to-person contact.
Cyclosporiasis is a foodborne illness caused by the protozoan Cyclospora cayetanensis. The parasite enters the body when a person ingests food or water contaminated with feces containing Cyclospora oocysts. Outbreaks of cyclosporiasis have been associated with eating certain types of imported fresh produce, in particular fresh cilantro, pre-packaged salad mix, raspberries, basil, snow peas, and various lettuces. Due to the Cyclospora lifecycle, it is unlikely the parasites can be spread through direct person-to-person contact.
Cyclospora parasites infect the small intestine and usually cause watery diarrhea with frequent and sometimes explosive bowel movements that can continue for several weeks.
Cyclosporiasis cases occur annually in Texas between May and August. The number of reported cyclosporiasis cases in Texas has been increasing every year since 2012.
 Cyclosporiasis is reportable in Texas. Confirmed and suspected positive cases of cyclosporiasis must be reported to the local or regional health department for the county of the patient’s residence within one week. The Laboratory encourages providers to submit all specimens linked to reported cases of cyclosporiasis to the DSHS Laboratory.
Cyclosporiasis is reportable in Texas. Confirmed and suspected positive cases of cyclosporiasis must be reported to the local or regional health department for the county of the patient’s residence within one week. The Laboratory encourages providers to submit all specimens linked to reported cases of cyclosporiasis to the DSHS Laboratory.
For more resources on Cyclosporiasis, visit CDC - DPDx - Cyclosporiasis and https://www.dshs.texas.gov/IDCU/disease/Cyclospora.aspx.
Cyclospora Testing at DSHS Austin Laboratory
Cyclospora cayetanensis detection and identification testing is available at the DSHS Austin Laboratory. The Laboratory collaborates each year with the Centers for Disease Control and Prevention (CDC) to identify and sequence Cyclospora specimens that could help connect cyclosporiasis cases in outbreak investigations. The DSHS Austin Laboratory encourages clinical laboratories to submit all appropriate Cyclospora positive stool specimens for molecular analysis. Please refer to the DSHS LTSM test menu for more details on Cyclospora testing at the Laboratory.
 Cysticercosis is an infection caused by the larval stage of the pork tapeworm Taenia solium. Humans can develop cysticercosis by eating food or drinking water that is contaminated with fecal matter containing T. solium eggs. Once ingested, the tapeworm eggs hatch and the larvae (cysticerci) move from the intestines into muscles or other body tissues where they form sac-like structures called cysts. These larval cysts can form in skeletal and cardiac muscle, skin, lungs, liver, and other organs. Larval cysts in the brain may result in the development of neurocysticercosis, which can lead to seizures, serious neurological complications, and, in severe cases, death.
Cysticercosis is an infection caused by the larval stage of the pork tapeworm Taenia solium. Humans can develop cysticercosis by eating food or drinking water that is contaminated with fecal matter containing T. solium eggs. Once ingested, the tapeworm eggs hatch and the larvae (cysticerci) move from the intestines into muscles or other body tissues where they form sac-like structures called cysts. These larval cysts can form in skeletal and cardiac muscle, skin, lungs, liver, and other organs. Larval cysts in the brain may result in the development of neurocysticercosis, which can lead to seizures, serious neurological complications, and, in severe cases, death.
 Cysticercosis and Taenia infections are reportable in Texas. Healthcare providers and laboratories are required to report both to the local or regional health department for the county of the patient’s residence within one week.
Cysticercosis and Taenia infections are reportable in Texas. Healthcare providers and laboratories are required to report both to the local or regional health department for the county of the patient’s residence within one week.
For more information on Cysticercosis and Taenia infections, visit Tapeworm (Taeniasis / Cysticercosis) | Texas DSHS and CDC - DPDx - Cysticercosis.
Taeniasis Testing at DSHS Austin Laboratory
Taenia spp. detection and identification tests are available at DSHS Austin Laboratory. Taeniasis is distinct from cysticercosis as it is caused by an adult tapeworm infection rather than larval cysticerci. Please refer to the DSHS LTSM test menu for more details on tapeworm testing at the Laboratory, including Taenia spp. testing and the Laboratory’s specimen submission and shipping requirements.
 Giardiasis is a gastrointestinal illness caused by the parasitic protist Giardia duodenalis (synonyms: G. lamblia, G. intestinalis). This parasite is commonly found in bodies of freshwater, including ponds, lakes, and streams, as well as in sources such as well water, stormwater systems, stagnant water. The organism’s ability to form cysts enables it to survive several months in cold water. Giardiasis infections occur worldwide but are more common in warmer climates.
Giardiasis is a gastrointestinal illness caused by the parasitic protist Giardia duodenalis (synonyms: G. lamblia, G. intestinalis). This parasite is commonly found in bodies of freshwater, including ponds, lakes, and streams, as well as in sources such as well water, stormwater systems, stagnant water. The organism’s ability to form cysts enables it to survive several months in cold water. Giardiasis infections occur worldwide but are more common in warmer climates.
The parasite enters the body when a person ingests food or water that has been contaminated with feces containing cysts. Fecally contaminated hands and objects can also spread the parasite. Once inside the body, the cysts undergo excystation, releasing infective trophozoites. The trophozoites adhere to the intestinal lining, where they consume nutrients. Trophozoites replicate, either forming more trophozoites or non-reproductive cysts, which are shed in feces. Acute symptoms of giardiasis range from asymptomatic to abdominal pain, nausea, vomiting, and severe diarrhea.  Chronic giardiasis can lead to nutritional deficiencies.
Chronic giardiasis can lead to nutritional deficiencies.
Giardiasis Testing at DSHS Austin Laboratory
Giardia duodenalis detection and identification in clinical specimens is available at the DSHS Austin Laboratory. Please refer to the DSHS LTSM test menu for more details on G. duodenalis testing. Specimen submission guidance is available on DSHS’ specimen submission and shipping requirements pages.
For more information on giardiasis, visit CDC - DPDx - Giardiasis
 Leishmaniasis is a disease caused by protozoan parasites belonging to over 20 different Leishmania species. The parasites are spread to humans by the bite of an infected sandfly. Immature parasites called promastigotes are injected into the skin when the sandfly bites. Phagocytes, a type of immune system cells, swallow the promastigotes near the site of the fly bite. The promastigotes multiply inside the immune cells, developing into an infective form. They later emerge from the cells to infect more immune cells. Depending on several factors, the parasites can go on to infect the skin, nose, and mouth, causing slow-healing ulcers.
Leishmaniasis is a disease caused by protozoan parasites belonging to over 20 different Leishmania species. The parasites are spread to humans by the bite of an infected sandfly. Immature parasites called promastigotes are injected into the skin when the sandfly bites. Phagocytes, a type of immune system cells, swallow the promastigotes near the site of the fly bite. The promastigotes multiply inside the immune cells, developing into an infective form. They later emerge from the cells to infect more immune cells. Depending on several factors, the parasites can go on to infect the skin, nose, and mouth, causing slow-healing ulcers.
 Leishmaniasis is reportable in Texas. Confirmed and suspected positive cases of leishmaniasis must be reported to the local or regional health department for the county of the patient’s residence within one week.
Leishmaniasis is reportable in Texas. Confirmed and suspected positive cases of leishmaniasis must be reported to the local or regional health department for the county of the patient’s residence within one week.
For more information on leishmaniasis, visit Leishmaniasis | Home (texas.gov) and CDC - DPDx - Leishmaniasis.
Leishmaniasis Testing at DSHS Austin Laboratory
Specimens for Leishmania spp. detection and identification testing are forwarded to CDC by DSHS Austin Laboratory. Submitters are required to receive pre-approval from CDC before submitting specimens directly to CDC for testing.
Specimens may be submitted to DSHS for referral to CDC, but submitters must first discuss the submission with the DSHS Laboratory and a DSHS epidemiologist. Call the parasitology team at 512-776-7560 or email Medical.Parasitology@dshs.texas.gov to discuss specimen submission options.
Please refer to CDC’s test directory here for more details on Leishmania spp. testing services at CDC. Refer to the DSHS LTSM test menu for a list of the referred leishmaniasis tests.
 Malaria is a serious and sometimes fatal disease caused by Plasmodium, a genus of obligate parasites. There are more than 100 species of Plasmodium, which can infect many animal species such as reptiles, birds, and various mammals. Four species of Plasmodium are recognized to infect humans: P. falciparum, P. vivax, P. ovale, and P. malariae. Several other species have been linked to malaria in humans, including P. knowlesi, which primarily infects primates. Plasmodium parasites are transmitted by the bite of an infected mosquito. These mosquitoes act as vectors, transmitting the parasites from one person to another.
Malaria is a serious and sometimes fatal disease caused by Plasmodium, a genus of obligate parasites. There are more than 100 species of Plasmodium, which can infect many animal species such as reptiles, birds, and various mammals. Four species of Plasmodium are recognized to infect humans: P. falciparum, P. vivax, P. ovale, and P. malariae. Several other species have been linked to malaria in humans, including P. knowlesi, which primarily infects primates. Plasmodium parasites are transmitted by the bite of an infected mosquito. These mosquitoes act as vectors, transmitting the parasites from one person to another.
Once the Plasmodium parasites enter the host’s body, they replicate asexually in the liver and then red blood cells. Successive broods grow inside the red blood cells, causing them to burst and release merozoites. Merozoites are the infective stage of the parasites that continue the cycle of infection by invading nearby red blood cells. Some of the parasites differentiate into sexual stages known as gametocytes. The gametocyte stage is referred to as a terminal phase since gametocytes are unable to reproduce sexually within the human host.
Plasmodium parasites in the bloodstream are responsible for the onset of the clinical symptoms associated with malaria. Symptoms include fever and flu-like illnesses such as shaking chills, headache, muscle aches, and tiredness. Nausea, vomiting, and diarrhea may also occur. Malaria can lead to anemia and jaundice. The yellow discoloration of the skin and eyes—a sign of jaundice—is due to the buildup of bilirubin in the bloodstream from the destruction of red blood cells. If not treated quickly, the infection can lead to severe complications such as kidney failure, seizures, cognitive impairment, unconsciousness, and death.
Plasmodium parasites in the bloodstream are responsible for the onset of the clinical symptoms associated with malaria. Symptoms include fever and flu-like illnesses such as shaking chills, headache, muscle aches, and tiredness. Nausea, vomiting, and diarrhea may also occur. Malaria can lead to anemia and jaundice. The yellow discoloration of the skin and eyes—a sign of jaundice—is due to the buildup of bilirubin in the bloodstream from the destruction of red blood cells. If not treated quickly, the infection can lead to severe complications such as kidney failure, seizures, cognitive impairment, unconsciousness, and death.
About 2,000 cases of malaria are diagnosed in the United States each year. Most cases are associated with international travel or involve individuals who have immigrated to the U.S. from regions where malaria is endemic.
 Malaria is reportable in Texas. Confirmed and suspected positive cases must be reported to the local or regional health department for the county of the patient’s residence within one week. The Laboratory highly encourages providers to submit specimens linked to reported cases of malaria.
Malaria is reportable in Texas. Confirmed and suspected positive cases must be reported to the local or regional health department for the county of the patient’s residence within one week. The Laboratory highly encourages providers to submit specimens linked to reported cases of malaria.
Malaria Testing at DSHS Austin Laboratory
Plasmodium species detection and identification, including microscopic examination and molecular testing through real-time PCR, are offered at the DSHS Laboratory for clinical specimens. Please refer to the DSHS LTSM test menu for more details on Plasmodium sp. testing. General specimen submission guidance is available on DSHS’ specimen submission and shipping requirements pages.
Providers are encouraged to submit confirmed and suspected malaria specimens to the DSHS Austin Laboratory for malaria surveillance.
How to Collect Blood and Prepare Blood Smears for Testing:
CDC - DPDx - Diagnostic Procedures - Blood Specimens (provided by CDC)
For more Malaria resources, visit:
Malaria | Texas DSHS and CDC at Malaria | Malaria | CDC and CDC - DPDx - Malaria
Primary amoebic meningoencephalitis (PAM) is a rare, sometimes fatal infection of the brain and central nervous system*. This condition is caused by Naegleria fowleri, a free-living ameba, which is most commonly found in soil and bodies of warm freshwater. It is also found in lakes, ponds, geothermal springs, warmwater effluent, household water heaters, and poorly maintained or minimally chlorinated swimming pools. The ameba’s ability to form cysts enables it to survive in hot water.
Naegleria fowleri (commonly called the “brain-eating ameba”) infects humans by entering the body through the nasal passage. This usually occurs when a person dives or swims in stagnant, warm water where the organism is present. Nasal irrigation with plain tap water can also transmit N. fowleri . Once in the nasal cavity, the organism travels to the brain where it consumes and destroys brain tissue. There is no evidence to suggest that N. fowleri can be transmitted between individuals or by drinking water containing the organism.
 Primary amoebic meningoencephalitis/naegleriasis is reportable in Texas. Confirmed and suspected positive cases must be reported to the local or regional health department in the county of the patient’s residence within one week.
Primary amoebic meningoencephalitis/naegleriasis is reportable in Texas. Confirmed and suspected positive cases must be reported to the local or regional health department in the county of the patient’s residence within one week.
*From 2009 to 2018, 34 N. fowleri infections were reported in the U.S. Of those cases, 30 people were infected by recreational water, three people were infected after performing nasal irrigation using contaminated tap water, and one person was infected by contaminated tap water used on a backyard slip-n-slide.
PAM/Naegleriasis Testing at DSHS Austin Laboratory
The DSHS Laboratory forwards clinical specimens to CDC for molecular identification by polymerase chain reaction (PCR) of N. fowleri. Submitters must provide the history of the presenting illness, the patient’s exposure history, past medical history, and treatment history. Specimens can be submitted to the DSHS Laboratory or shipped directly to CDC. Specimens should not be submitted directly to CDC without pre-approval from CDC.
Refer to the DSHS LTSM test menu for more details on PAM/Naegleriasis testing at the CDC Laboratory. General specimen submission guidance is available on DSHS’ specimen submission and shipping requirements pages.
For more information on PAM, visit DSHS Infectious Disease Control webpage on the condition, found here, and CDC information found at CDC - DPDx - Free Living Amebic Infections.
 Strongyloidiasis is a disease with a range of skin, respiratory, and gastrointestinal symptoms. It is caused by multiple species of Strongyloides roundworms. The roundworms are commonly spread by exposure to soil and water contaminated with feces. Strongyloides stercoralis is the species that is most frequently associated with human infections. While Strongyloides is typically found in tropical regions of the world, it has also been identified in various areas of the northeastern, southern, and southwestern United States.
Strongyloidiasis is a disease with a range of skin, respiratory, and gastrointestinal symptoms. It is caused by multiple species of Strongyloides roundworms. The roundworms are commonly spread by exposure to soil and water contaminated with feces. Strongyloides stercoralis is the species that is most frequently associated with human infections. While Strongyloides is typically found in tropical regions of the world, it has also been identified in various areas of the northeastern, southern, and southwestern United States.
Strongyloides stercoralis larvae enter the body through the skin. They then typically move to the small intestine where they mature. Intestinal infection by the worms can lead to abdominal pain and diarrhea or constipation. Larvae that hatch from eggs in the small intestines are excreted into the environment in feces, where they continue their infective lifecycle. Autoinfection can happen when larvae in the intestines penetrate the intestinal wall and infect other parts of the body such as the lungs, skin, and throat, which can lead to chronic infection. Skin rashes and itching at the site of entry are also symptoms of infection. Chronic infections can lead to complications such as arthritis, cardiac arrhythmias, and asthma.
For more information on Strongyloidiasis, visit CDC - DPDx - Strongyloidiasis.
Strongyloides Testing at DSHS Austin Laboratory
Detection and identification services for Strongyloides stercoralis are provided by the DSHS Austin Laboratory. In addition, the Laboratory offers serological tests for detecting Strongyloides infection. Please refer to the DSHS LTSM test menu for more details on S. stercoralis testing at the Laboratory. Specimen submission and shipping requirements are available here.
 Trichomoniasis is an infection caused by the protozoan parasite Trichomonas vaginalis, which is the most widespread pathogenic protozoan of humans in industrialized countries. Humans are the only known host of T. vaginalis as it does not survive long outside the body. It is mainly transmitted through sexual contact so is classified as a sexually transmitted infection (STI). Cattle trichomoniasis, an STI of cattle is caused by a different Trichomonas species, T. foetus.
Trichomoniasis is an infection caused by the protozoan parasite Trichomonas vaginalis, which is the most widespread pathogenic protozoan of humans in industrialized countries. Humans are the only known host of T. vaginalis as it does not survive long outside the body. It is mainly transmitted through sexual contact so is classified as a sexually transmitted infection (STI). Cattle trichomoniasis, an STI of cattle is caused by a different Trichomonas species, T. foetus.
In humans, T. vaginalis attaches to cells lining the urogenital tract, where it replicates. Infected males are frequently asymptomatic whereas females are frequently symptomatic, with cervical lesions, abdominal pain, and painful urination.
For more resources on (human) trichomoniasis, visit CDC - DPDx - Trichomoniasis
Trichomoniasis Testing at DSHS Austin Laboratory
Trichomonas vaginalis susceptibility testing is available at CDC. Healthcare providers seeking trichomoniasis testing must first contact the DSHS Parasitology Team before submitting specimens to DSHS for forwarding to CDC for testing. Specimens should not be submitted directly to CDC without pre-approval from CDC.
Please refer to the DSHS LTSM test menu for more details on Trichomonas CDC referral testing. General specimen submission guidance for the DSHS Laboratory is available on DSHS’ specimen submission and shipping requirements pages.
Toxocariasis is a parasitic infection in humans caused by the larvae of dog roundworms (Toxocara canis), or cat roundworms (T. cati). Infection can occur in humans when they come into contact with eggs shed in the feces of dogs or cats and subsequently ingests them. After entering the body, the eggs hatch, and the larvae migrate through the intestinal wall into the bloodstream, skeletal muscles, or other bodily tissues, resulting in inflammation and damage. Organs such as the heart, liver, lungs, and eyes may also be affected, although some individuals may not exhibit symptoms. Migration of the larvae to the central nervous system can lead to neurological issues.
For more information on toxocariasis, visit CDC - DPDx - Toxocariasis.
Toxocara Testing at DSHS Austin Laboratory
The DSHS Laboratory forwards serum specimens from healthcare providers and laboratories to CDC for Toxocara spp. serology testing. Please refer to the CDC test directory here for more details on available Toxocara testing service. General specimen submission guidance for the DSHS Laboratory is available on DSHS’ specimen submission and shipping requirements pages.